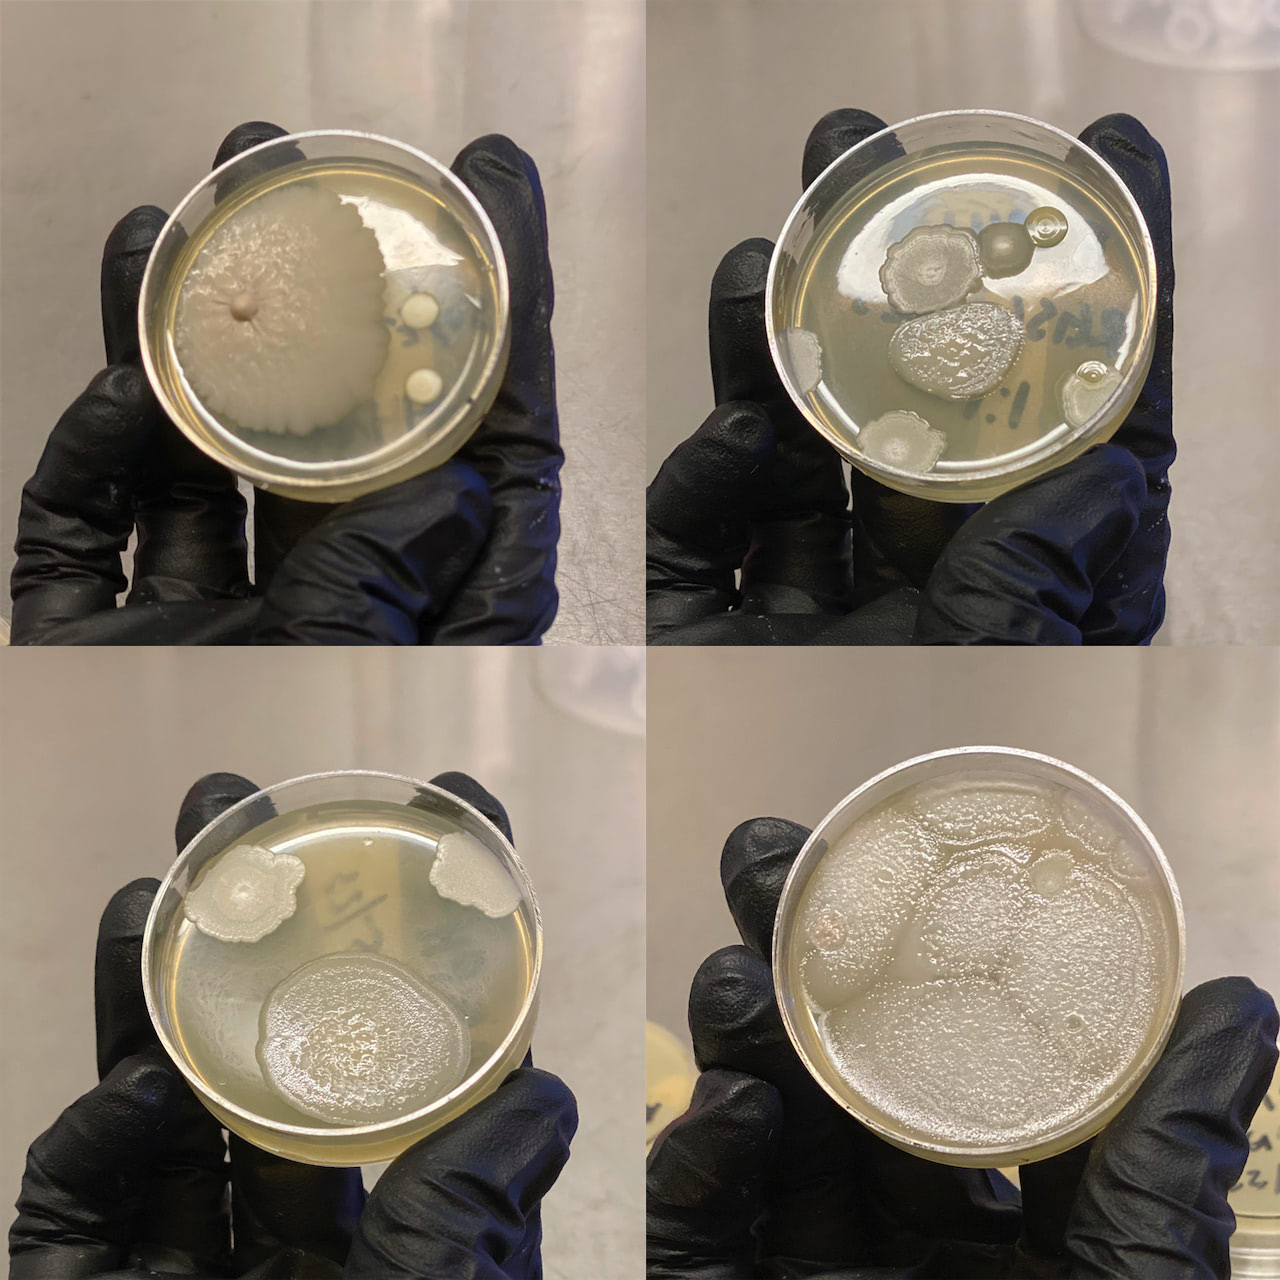
在纽约的蜂蜜样本中发现的天然存在的微生物菌株 / Naturally occurring microbial strains found in NY honey samples

Shuyi Cao与Remina Greenfield,生活及工作于纽约的艺术家及研究者,她们共同创办了实验性艺术团体Decompose。Decompose探索游走于正式与非正式体制架构的跨学科工作模式,研究涉及生态学、信息理论和生命系统,创作产出包括但不仅限于物质媒介,组织形式,对话与写作,以及社群建设。
何梦兮,算法工程师,专注于数字科技及其在建筑,艺术领域的应用。
温柔啃噬
2021
分子数据动画
微生物是构成我们身体与环境的无形消化器。微观代谢的炼金术,通过分解有机化合物在生物材料之间进行转化;葡萄化为佳酿,牛奶化为乳酪,腐尸化为尘土。发酵是由微生物主导的腐烂,只是在其产出可供人食用并引发愉悦或陶醉的时候才被赋予不同的名称。这件作品呈现了发酵的数字空间,通过光与影的瞬息流动,描绘了微生物发酵过程中平缓、渐进与不可见的分子波动。分子数据采集于艺术家在实验室对蜂蜜发酵的研究,通过算法模拟生成的动态循环,创造出新的数字建构,气体与液态的转化呈现一种生成与分解的共时状态。